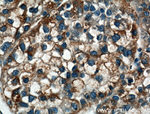
LRG1 Antibody in Immunohistochemistry (Paraffin) (IHC (P))

Search
Proteintech
LRG1 Polyclonal Antibody
{{$productOrderCtrl.translations['antibody.pdp.commerceCard.promotion.promotions']}}
{{$productOrderCtrl.translations['antibody.pdp.commerceCard.promotion.viewpromo']}}
{{$productOrderCtrl.translations['antibody.pdp.commerceCard.promotion.promocode']}}: {{promo.promoCode}} {{promo.promoTitle}} {{promo.promoDescription}}. {{$productOrderCtrl.translations['antibody.pdp.commerceCard.promotion.learnmore']}}
产品信息
13224-1-AP
种属反应
已发表种属
宿主/亚型
分类
类型
抗原
偶联物
形式
浓度
规格
纯化类型
保存液
内含物
保存条件
运输条件
产品详细信息
Immunogen sequence: DCQVFRSDH GSSISCQPPA EIPGYLPADT VHLAVEFFNL THLPANLLQG ASKLQELHLS SNGLESLSPE FLRPVPQLRV LDLTRNALTG LPSGLFQASA TLDTLVLKEN QLEVLEVSWL HGLKALGHLD LSGNRLRKLP PGLLANFTLL RTLDLGENQL ETLPPDLLRG PLQLERLHLE GNKLQVLGKD LLLPQPDLRY LFLNGNKLAR VAAGAFQGLR QLDMLDLSNN SLASVPEGLW ASLGQPNWDM RDGFDISGNP WICDQNLSDL YRWLQAQKDK MFSQNDTRCA GPEAVKGQTL LAVAKSQ (42-347 aa encoded by BC034389)
靶标信息
The leucine-rich repeat (LRR) family of proteins, including LRG1, have been shown to be involved in protein-protein interaction, signal transduction, and cell adhesion and development. LRG1 is expressed during granulocyte differentiation.
仅用于科研。不用于诊断过程。未经明确授权不得转售。
生物信息学
蛋白别名: 1300008B03Rik; 2310031E04Rik; A2GL; leucine rich alpha 2 glycoprotein; Leucine-rich alpha-2-glycoprotein; Leucine-rich alpha-2-glycoprotein precursor; LRG; LRG 1; LRG-1; unnamed protein product
基因别名: 1300008B03Rik; 2310031E04Rik; HMFT1766; LRG; LRG1; Lrhg
UniProt ID: (Human) P02750
Entrez Gene ID: (Human) 116844, (Mouse) 76905